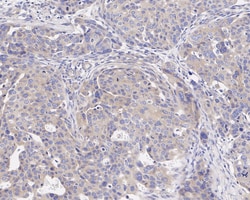
Invitrogen GSK3 alpha Recombinant Rabbit Monoclonal Antibody (JE33-27)

missing translation for 'onlineSavingsMsg'
Learn More
Learn More
Invitrogen™ GSK3 alpha Recombinant Rabbit Monoclonal Antibody (JE33-27)


Rabbit Recombinant Monoclonal Antibody
Marque: Invitrogen™ MA556488
Les retours ne sont pas autorisés pour ce produit.
Afficher la politique du retour.
Description
GSK3 alpha Recombinant Monoclonal Antibody for Western Blot, IHC (P)
Glycogen synthase kinase 3 alpha (GSK3A) is a multifunctional protein serine/threonine kinase implicated in the control of several regulatory proteins and transcription factors. (GSK3A Alias: DKFZp686D0638). Human GSTs can be divided into five main classes: alpha, mu, pi, theta, and zeta. The theta class includes GSTT1 and GSTT2. The GSTT1 and GSTT2 share 55% amino acid sequence identity and both of them were claimed to have an important role in human carcinogenesis. The GSTT1 gene is located approximately 50kb away from the GSTT2 gene. The GSTT1 and GSTT2 genes have a similar structure, being composed of five exons with identical exon/intron boundaries.
Spécification
| GSK3 alpha | |
| Recombinant Monoclonal | |
| 1 mg/mL | |
| TBS with 0.05% BSA, 40% glycerol and 0.05% sodium azide; pH 7.4 | |
| P18265, P49840, Q2NL51 | |
| Gsk3a | |
| Synthetic peptide within Human GSK3 alpha aa 50-150. | |
| 100 μL | |
| Primary | |
| Human, Mouse, Rat, Monkey | |
| Antibody | |
| IgG |
| Immunohistochemistry (Paraffin), Western Blot | |
| JE33-27 | |
| Unconjugated | |
| Gsk3a | |
| 2700086H06Rik; DKFZp686D0638; FA; factor A; glycogen synthase kinase 3 alpha; glycogen synthase kinase 3 alpha b; glycogen synthase kinase 3 alpha b; glycogen synthase kinase-3 alpha; glycogen synthase kinase-3 alpha; GSK3; GSK-3 alpha; GSK-3[a]; GSK-3[b]; gsk3a; gsk3ab; gsk-3-alpha; OTTHUMP00000198368; Serine/threonine-protein kinase GSK3A | |
| Rabbit | |
| Protein A | |
| RUO | |
| 2931, 50686, 606496 | |
| Store at 4°C short term. For long term storage, store at -20°C, avoiding freeze/thaw cycles. | |
| Liquid |
Correction du contenu d'un produit
Veuillez fournir vos retours sur le contenu du produit en remplissant le formulaire ci-dessous.
Nom du produit
Vous avez repéré une opportunité d'amélioration ?Partager une correction de contenu